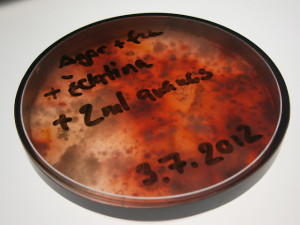

Table of Contents
Project Biolab
~~META: status = active &relation firstimage = :project:10076716473_fb5380cf36.jpg ~~
- name:
- Project Biolab
- statu:
- active
- image:
- {{:project:dna.jpg}}
Goals
The goals of this project:
- Lab for everyone - enable access to experimental biology for everyone with interest and basic knowledge of biology, unrelated to formal education. We do not need you to have a degree, just curiosity and a willingness to learn is enough. Just stopping by to say hi is welcome as well - we're here to allow everyone to get acquainted with usually inaccessible laboratory procedures, try them out, learn some basics or start a project.
- Do it yourself - give an opportunity to everyone with interesting ideas for experiments and try to reproduce what normally is done in big labs with as little need for professional equipment as possible - in the spirit of the DIY Bio movement.
- No Fear! - showing that biology, biochemistry and genetics can be done safely in relatively simple conditions. There's a lot that can be done with basic tools and in accordance with the laws - you can't make GMOs at our lab, but you can use molecular genetics to identify meat content in your breakfast, for example.
Our interests (can change if a new member arrives!):
- bacteria, algae and plant cultivation
- DNA isolation and analysis
- heredity and development experiments
- DNA security
- behavioral studies (see BrmRat)
- electrophysiology (see Elektrostimulace chutoveho senzorickeho aparatu)
- histology (see BrmHistology)
- mapping of interesting organisms (see BioOSM)
Contact us!
Currently the core team of biolab is: chido, sachy, Jenda, pasky, mrkva, sumie-dh and bluebear. Various other members of brmlab conduct occasional experiments. Contact anyone of us - we'll be glad to show you around in person aswell.
We also have a mailinglist: biolab@brmlab.cz (archives).
The Lab
The Biolab is a large room located in the main hackerspace premises, right next to the chemistry-focused laboratory, chemlab. The two projects cooperate closely with eachother and share some equipment, but at the same time have their own workspaces and designated material storage to assure safety and viability of both chemistry-related and biology-related work. If you are interested in the chemlab project, or would like to use their equipment or material, contact sachy.
We started out in a small space behind the brmlab kitchen: Panoramatic view of the old lab
We have recently moved to a new place!
TODO Pictures!
We now have larger premises housing a lab bench, a large microscope (dubbed the macroscope), several smaller optical microscopes, a large freezer, a fridge, a set of micropipettes, an elecrophoresis chamber with power supply, an OpenPCR thermocycler, a shaker, precision scales, a microwave, a biological incubator, a flowbox and basic lab equipment like pipette tips, glassware, chemicals etc.
Donations of material are always welcome, since we are self-funded. Contact sumie-dh or sachy if you have something you would like to contribute! We do not accept dangerous chemicals or other explicitly harmful materials.
How to behave in biolab
First and foremost, don't be shy visit - if the door is open, just walk in and say hi, if it's closed, ask a brmlab member to accompany you!
In order for the biolab to be able to function safely and be available to a large community of people as equally as possible, there are some basic rules:
- Keep the place clean. If your work is done, put the place back in order for the next person to make a mess of :) This means wash used tools and glaseware properly, keep containers closed and the bench clean.
- No foods and drinks on the workbenches, inside the freezer, fridge or microvawe. There's a chill-out corner sharing space with the biolab room, food and drink can be consumed there.
- Do not leave unlabeled and open containers in the lab. If you want to store something or have a longer-running experiment on the bench, it's no problem to leave it there - just make sure to label it with your name, what it is, and the date you put it there. For safety reasons, unlabeled stuff will be disposed of without prior notice.
- You can use all the equipment present. However, some of the machines require at least a small initial introduction on how to use them without you or the machine in question sustaining any damage. We're assuming the microwave is safe in your hands :) but: talk to sumie-dh if you want to use the macroscope and to chido if you'd like to play with the electrophoresis chamber and open PCR.
- Discuss your projects with the community. Basically, anything goes that's safe and legal when it comes to projects you would like to introduce to the lab. But in order to keep the lab a safe and fun place to everyone involved, please talk to sumie-dh about your biolab project and to sachy about your chemlab project first.
- Some storage places are locked. Because the hackerspace is open to the public, and some of the reagents are potential health hazards or expensive, we keep the storage locked and an inventory registry. If you would like to access to both, members can help you out.
- Be nice to eachother. No, really, this is important :)
- If you want to store private equipment or material in the lab, put it in a separate box labeled with your name.
Equipment
What we already have:
- OpenPCR
- Various microscopes
- Centrifuge
- Micropipetes
- Biomarkers
- big biological incubator
- flowbox
What we'd like to have:
- a more precise microscope
- strong light source (for growing plants)
- shaker and vortex
- always welcome:
- agarose (PCR-grade is most welcome
)
- more material (pipette tips, lab glass…)
- microtome
- some DNA ladders
- some restriction enzymes
- tips for micropipettes
- bigger centrifuge for better DNA isolation
- 260/280nm spectrophotometer would be great for measuring DNA quantity and quality
If you can and want to support the lab with material donation (listed or otherwise), contact the core team (or anyone else in brmlab).
What have we done so far
Electrophoresis hackathon
 We hosted the Electrophoresis: Collective Building Hackathon in September 2013, where
chido held an introductory lecture on molecular genetics, how gel electrophoresis works and what it is used for. We made agar gel, experimented with various power supplies and UV sources for visualizing the gel. Great pictures from the event can be found here: http://www.flickr.com/photos/85181478@N07/sets/72157636165317593/
We hosted the Electrophoresis: Collective Building Hackathon in September 2013, where
chido held an introductory lecture on molecular genetics, how gel electrophoresis works and what it is used for. We made agar gel, experimented with various power supplies and UV sources for visualizing the gel. Great pictures from the event can be found here: http://www.flickr.com/photos/85181478@N07/sets/72157636165317593/
Extracting DNA
Extracting DNA - originally inspired by Strawberry Mayhem. Fruit juice + jar + salt + isopropyl = DNA!
chido tried several fruits - strawberries, melons, oranges, bananas, plums, peaches. It was a big success! Strawberries seem to be working very well, there were similar results with plums and peaches. Both were relatively easy to mash and mix with the solvent (detergent “Jar” + water + salt) and filtered nicely. Melons and oranges also mash and filter easily but due to their watery nature do not result in a usable amount of DNA material due to their watery nature (less nuclei per amount of fruit flesh?). Banana did not work at all, after getting mashed and mixed with solvent only an insignificant amount of liquid passed through the filter due to the sticky and very dense nature of the fruit.
DIY Microscopes

The BrmScope is now situated in the biolab and connected to Hind3, the local PC. For instructions on how to use it, see the project site (there is a short note on the wall at the lab too :) )
Another set-up we experimented with was a laser microscope: a makeshift apparatus that uses a 1 mW green laser and a scaffolding holding a suspended syringe in front of it. The drop of water at the tip of the syringe refracts the laser beam and projects a magnified image of the drop content on the wall. Works nicely - we examined the following suspensions: Water filtered through the earth of a pot plant, Blaptica dubia droppings, mucus and blood. Each time we observed a different content. After leaving the first sample (pot plant earth) in a glass for two days, the content seems to have tripled. Pictures from the first iteration
Chlorophyll Extraction and Study of Fluorescence
We used a leaf sample from Primula vulgaris as source for the chlorophyll. To break up cell walls, we suspended the leaf in liquid nitrogen and proceeded to ground it to a fine powder once the nitrogen evaporated. After adding isopropyl alcohol, we centrifuged the suspension using a disassembled hard drive as centrifuge, until all the remaining residue collected at the bottom. When exciting the resulting suspension with UV light, the chlorophyll emitted red light. Pictures from the experiment
Centrifuge

We are enhancing the hard disk based centrifuge to have build instructions and proper control software and solid hardware:
- WIP: Hard disk plates replaced with dremelfuge-like reprapped holder
- We need to put holder sources on thingiverse
- DONE: Hard disk with electronics ripped off
- DONE: Noname HobbyKing 20A ESC brushless motor controller soldered on motor pins instead
- WIP: Arduino controls the ESC
- The ESC keeps resetting and losing calibration settings
- WIP: RPM turning speed detection and control
- CNY70 provided by Nephirus + collector-sense circuit + duct tape and black marker
- TODO: Resolder on mini-PCB, more robust construction and wiring
- TODO: Dynamic motor control for “RPM hold” (we need reliable ESC control first)
- TODO: Port sketch to LaunchPad, swap with Arduino
- TODO: Control software for PC
Arduino sketch: centrifuge-sketch CAD file: centrifuge-scad Currently, we are able to attain 6200 RPM (without eppendorfs). Maybe we are not at the limit yet.
Operant conditioning chamber for cognitive experiments on rats
This project has graduated to a separate page! See Conditioning Chamber for Cognitive Experiments for details.
Taste Receptor Electrostimulation
Current Projects
~~DIRPICTURES sortByDate sortDesc~~
BioOSM
Some members are collecting photos and other evidence of (micro)organisms which can (not) be seen from behind the computer screen. Please see the BioOSM project pages. Project is closely knitted with Planarian working group.
Planarian working group
External project led by sumie-dh. Project is beyond 'normal' naturalist way of doing and following certain goals and plans. If you want taste topics like how to deal with unknown [possibly] new species in your collections, how to manage fieldwork plans, messing with keys and searching for resources, research ideas and workflow designs in taxonomy, curating of own sample collection in +- standardized ways, WSI processing and dealing with presentation of your results outside of 'hackerspace setup' talk to members of planarian working group > sumie-dh| sachy. Forget anything DIY in this project ;]
Overview of currently solved topics is on: https://bioosm.brmlab.cz/histolka/project_imagery/project_imagery.htm Note this is only fragment of running things, we are going on own pace, slowly but surely forward, this is speed of planarian.
Onboarding of new members: unlikely but discuss it with members.
Planarian samples welcomed but keep permit logic in mind in case of foreign samples or those from local national parks.
Finished fieldwork sessions:
- 2024: First record of the land planarian species Rhynchodemus sylvaticus (Leidy,1852) in a naturalized area of Czechia [manuscript soon, waiting for DNA barcoding]
- 2023-2024: Sexual strains of Girardia tigrina in Central Bohemian region - self-funded, further work ongoing
- 2022: Mapovánı́ ploštěnky Dugesia gonocephala v povodı́ Svinenského potoka - grant CSOP_122210, further work ongoing
- 2021: Mapovánı́ ploštěnky Crenobia alpina v okolı́ Hojné vody - grant CSOP_122123
Epoxidation of samples
Recently we learned how to pour our macroscopic samples into a transparent epoxide to be able to show them without risking damage. No more fridges full of formaldehyde bottles :)
PCR and electrophoresis
See PCR
Fun with Bioluminescence
GFP rats, GloFish and even GFP yeasts (for glowing beer) are forbidden by EU, but we can still play with natural non-GM bioluminescent organisms:
- bioluminescent algae - there are several species of bioluminescent marine dinoflagellates http://www.instructables.com/id/Grow-Your-Own-Bioluminescent-Algae/
- bioluminescent bacteria - it is possible to isolate bioluminiscent bacteria from fresh (non-frozen) marine fish, shrimps or squids http://www.splammo.net/bact102/102lumbact.html
- bioluminescent fungi - there are many species, some native in the Czech Republic http://en.wikipedia.org/wiki/List_of_bioluminescent_fungi
Bioluminescent bacteria can be used for water pollution detection:
what is needed
- establish basic microbiology workflow
- autoclave - pressure cooker (121 °C)
- strong light source + timer
- f/2 Medium for coastal marine algae: https://ncma.bigelow.org/node/83 (but we may try luck with simplified medium, see below)
- sea salt (aquarium - not kitchen - grade)
- NaNO3
- NaH2PO4*H2O
- Na2SiO3*9H2O
EDTA- FeCl3*6H2O
MnCl2*4H2OZnSO4*7H2OCoCl2*6H2OCuSO4*5H2O- Na2MoO4*2H2O
H2SeO3NiSO4*6H2O- Na3VO4
K2CrO4- thiamine HCl (vitamin B1)
are vitamins needed? http://www.ncbi.nlm.nih.gov/pmc/articles/PMC1539151/
- biotin (vitamin H/B7)
cyanocobalamin (vitamin B12)
- medium for marine bacteria:
glycerolagar- sea salt (aquarium grade)
- yeast extract
- peptone/tryptone
- calcium carbonate
Just an (untested) idea for simplified algae medium: sea salt + nitrate + phosphate + soil extract + B-complex (incl B1/7/12) (but we need to find B-complex with minimum added sugar, possibly i.v. solution?)
Playing with microorganisms
- investigate possible ways how to grow bacteria colonies and fungi using homebrew equipment and chemicals
- agar (surprisingly cheap), maybe mixed with sugar
- broth (hovězí vývar)
- incubator with controlled temperature (peltier cell), humidity and illumination
- Is it possible to do gram staining with standard hackerspace technology?
- grow some grampositive bacteria in petri dishes, add Penicillium chrysogenum (at best) and see what happens :)
- BioStrike project: gamify open drug discovery of antibiotics over Petri dishes, See BioStrike: Open Antibiotics Discovery
Interresting reading:
Planned Projects
Enzyme extraction
Enzymes for DNA experiments (thermostable DNA-p, restriction endonucleases…) can be ordered online, but the price is really high (1000 USD). Extracting them ourselves will be a great project that may grant access to advanced gene technology to the masses!
Other Possible Projects
- Replicating a genetic experiment with vegetative hybridization of tomatoes https://web.natur.cuni.cz/flegr/pdf/lysenk.pdf
- devising experiments for MyxoBrm aneb HlenkoBrm
- grow plants on agar in sealed jars
- microbial power cells
- bioprinting
- for the next sailing trip: http://www1.plymouth.ac.uk/marine/secchidisk/Pages/default.aspx
- …feel free to suggest your own projects!
References
- Great introductory website to the world of genetics: http://learn.genetics.utah.edu/
- DIY Bio movement: http://diybio.org/
- Summary of available methods and latest state-of-the-art DIY Bio: http://letters.cunningprojects.com/?p=132
- It's opensource! http://bbf.openwetware.org/
- (expensive) DYI gel elecrophoresis: http://www.pearlbiotech.com/
- The homepage for any biohacker: http://partsregistry.org/Main_Page
- Pocket PCR for pennies (work in progress): http://lava-amp.com/
- Neuroscience for everyone! http://backyardbrains.com/Spikerbox.aspx






